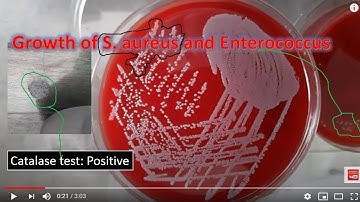
Staphylococcus and Enterococcus on blood agar and use of catalase test

⬇ DOWNLOAD NOW
Kalau muncul iklan pop-up, tutup lalu klik tombol kembali
Download lagu staphylococcus and micrococcus part 1 secara gratis hanya untuk keperluan promosi. Dukung artis favorit kamu dengan membeli musik original di iTunes atau platform resmi lainnya.
 Staphylococcus: Aureus, Epidermidis, Saprophyticus
Staphylococcus: Aureus, Epidermidis, Saprophyticus
 Staphylococcus species (Characteristics, Clinical complications, Differences)
Staphylococcus species (Characteristics, Clinical complications, Differences)
 Staphylococcus || Flow chart 🔥|| Aniket tyagi
Staphylococcus || Flow chart 🔥|| Aniket tyagi
Staphylococcus and Enterococcus on blood agar and use of catalase test
Staphylococcus and Enterococcus on blood agar and use of catalase test
 Gram Positive Cocci Part 1 Staph
Gram Positive Cocci Part 1 Staph
 MT Pre-Recorded Lectures | MT 37: Biochemical Testing (Staphylococcus & Micrococcus Part 1)
MT Pre-Recorded Lectures | MT 37: Biochemical Testing (Staphylococcus & Micrococcus Part 1)
 Staphyloccus - Practical
Staphyloccus - Practical
 Microbiology: GPC, GNC, GNCB Colonial Growth on BAP & CHOC
Microbiology: GPC, GNC, GNCB Colonial Growth on BAP & CHOC